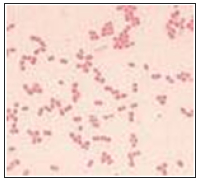
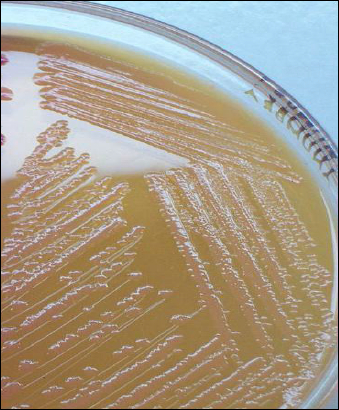

- Gram-negative bacilli ( coccobacillary morphology on nonselective agar)
- Predominantly diplococci
- Non-motile
- Strictly aerobic
- Catalase-positive
- Oxidase-negative
- Nitrate-negative
- Non-fermentative
- Citrate (+)
- Urease (-)
- Indole (-)
- Picture below shows Acinetobacter colonies on Blood agar, 0.5 – 2mm in diamater, translucent to opaque, convex, smooth surface and entire margins
- On MacConkey agar: non lactose fermenting colonies
Acinetobacter Can cause:
- Bacteremia
- Urinary tract infection
- Meningitis
- Nosocomial pneumonia especially (Ventilator-associated pneumonia)